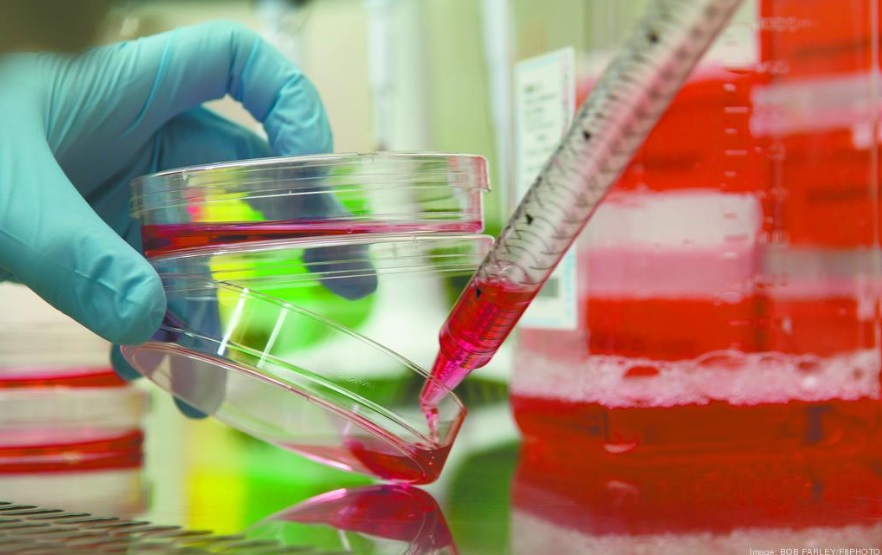

Scientists of a genetic engineering company have claimed they have developed a vaccine for the deadly novel coronavirus.
As Houston-based Greffex Inc. explained to Houston Business Journal, they have developed the much-anticipated vaccine and prepared it for testing on animals.
The good news follows weeks after scientists from labs from all around the world have begun racing to develop a vaccine for the coronavirus that has already infected over 70,000 people worldwide.
While the development of the vaccine represents a major breakthrough in countering the outbreak, independent experts have suggested that it could take up to two years before it is properly tested, approved, and produced for mass use.
As the company behind the vaccine explained, they didn’t want to risk exposure to a hazardous situation by using the virus itself in the creation of a vaccine.
Instead, Greffex confirmed that they have developed a vaccine on the basis of adenovirus, a virus that is commonly responsible for viral respiratory infections and often used in the development of vaccines.
“The trick in making a vaccine is can you scale the vaccine that you’ve made to be able to make a certain number of doses, can you test the vaccine quickly and efficiently and then can you get it into patients – and that’s where we have an edge on the other companies that are out there,” the company’s CEO, John Price, said in an interview with KHOU.
With the vaccine ready for testing, scientists are looking forward to running animal tests before proceeding to clinical trials involving human subjects.
Following several human trials, the vaccine will be facing a review by the Food and Drug Administration (FDA) and mass production considering it gets approved.
What are your thoughts on this story? Let us know in the comments and don’t forget to SHARE this post with your family and friends and follow us on Facebook for more news and stories!
Replaced!